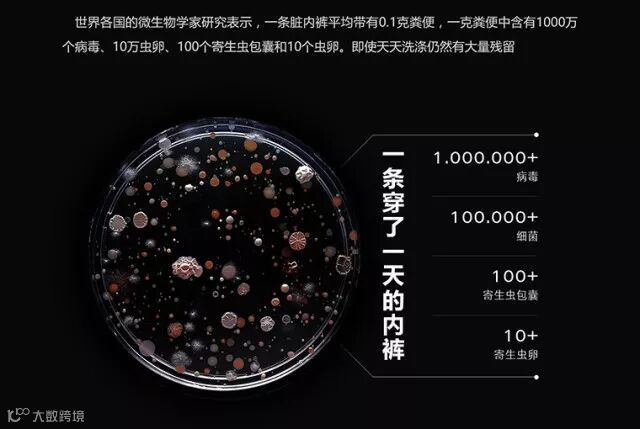

曾经有老铁和在下炫技:一条内裤可以穿4天,正面穿2天,反过来还能再穿2天。当然还是比不过这对好基友,2条内裤从小穿到大。
可见,在大多数男生的全身装备中,最受歧视的大概就是内裤了。穿到地老天荒,甚至起球、破洞、变形也懒得买新的。
内裤虽小,但作为贴身物品却存在很多看不见的安全隐患,甚至关系到你小伙伴茁壮成长的问题!同时它也代表了一种表里如一的生活态度!
所以军武菌经过多方测评和学习,终于找到一款超合心意的内裤。大概会穿一辈子!今天就来和大家一起来分享这些心得!
TIP1:一条脏内裤平均带有0.1克粪便,再不杀菌就成培养皿啦!!
内裤作为人体的第二层肌肤,保护着人体最私密的三角区。终日不见阳光,汗液、尿液滴落等物质。简直就是病毒、细菌滋生的重灾区。
这些细菌虽然看不见,但是会导致私密处红肿、瘙痒等情况,甚至引发各类生殖健康问题!
谈到细菌,市面上已经有很多抗菌内裤了。大部分是添加了银成分的除菌内裤。Ag+(银离子)确实是科学家和医生公认的杀菌效果最好的物质。甚至很多高端饮水机也开始采用银离子进行杀菌~
然而市面上大多数打着纳米银噱头的内裤,其实是在面料加工完后期,在表面添加了抗菌剂。经过洗涤后纤维表面会被破坏,抑菌效果就渐渐失效了!
而军武菌要和大家分享的这款内裤。其面料中含有Airclean银离子抗菌材料。
它是在纤维熔体阶段就加入了银离子(纱线还没形成前),使银离子可以均匀分布在纤维内部和表面。
可以达到近乎永久的抗菌效果,不因洗涤多次而失效。经过3A级抗菌检测(洗涤50次后抑菌率依旧大于99%)。这种加工技术成本极高,简直是洁癖患者的福音!
最良心的是整个内裤的面料都含有Airclean银离子抗菌材料。以前军武菌在某宝买过类似的内裤,结果买回来发现,只有裆部是抗菌面料,其他地方还是普通棉质!
360度防护您的健康,成本自然不同。
TIP2:要如何选择内裤的面料呢?
在选择内裤时,什么面料的更好呢?其实军武菌的要求并不多,柔软舒适,吸湿透气,出汗后能快干就行了~
市场上一些内裤品牌,为了迎合消费者的心理(手感越好,质量越好),在面料后整理时,明明是较差的原材料,通过加大量的硅油,可以让面料手感细滑,却不透气。水滴入后,呈荷叶状,吸湿透气性差。
军武菌早期穿的最多的就是纯棉内裤,棉质内裤有个好处就是穿起来比较舒服透气,但是湿了不容易干。对于像军武菌这种运动健将爱出汗的人来说,实在不舒服!到了夏天就算不动也总是湿漉漉的!
梅雨季的南方汉子更是不敢想象~要是不快干,大概可以种蘑菇了~
而军武菌和大家分享的这款内裤,面料含有43.5%的超细旦兰精莫代尔,是莫代尔中的精品。
是由奥地利的兰精公司从榉木中提取的纤维,天然环保且可降解。
60支数的超细旦兰精莫代尔,不会像纯棉越洗越硬还显旧。多次洗涤依旧柔软舒适,光滑细腻。穿上后几乎感觉不到它的存在~而且莫代尔纤维的强度比棉纤维要高,更加耐穿!
而针对快干的需求,面料中还加入了44.5%的异形截面聚酯纤维。纤维截面呈十字形,形成的沟槽可以迅速导出人体汗液。皮肤时刻保持干爽透气,也减少了细菌在潮湿环境的滋生。
另外针对不同部位的需求,下档部位还特意采用了鸟眼结构,更加透气且透而不漏。排汗透气效果翻倍提升,尽情呼吸。
为了证明这是一条会呼吸的内裤,军武菌特意在商场买了某品牌内裤,做了水滴对比试验。水滴滴落,迅速吸湿扩散,快干效果肉眼可见。
我们的内裤已经干了,而品牌内裤才刚刚开始扩散。
面料舒适透气又快干,环保染色,1小时浸泡加搓揉没有任何掉色!
TIP3:内裤弹性不仅仅是舒适,还关乎我们的健康!
选择内裤一定要选择弹性好的,否则同样会引发许多问题。泌尿科大夫发现,不少小兄弟变形,出现不同程度的弯曲。究其原委,与常穿紧身内裤难辞其咎。
在弹性方面,通常内裤加的都是氨纶。而这款内裤采用的是美国杜邦公司最好的弹力纤维莱卡。光原料成本就是普通氨纶的3倍。四向弹力不紧绷,方便身体的舒张。强韧的弹力与回弹性,也更加的耐穿耐洗,不容易变形。
TIP4:贴心实用的设计细节
款式也是军武菌特别喜欢的平角裤,在行走和运动时,长裤脚让大腿再也不会磨的难受了,穿着更舒适!
采用3D立体裁剪技术,严格按照亚洲人体型3D裁剪,合体告别松懈。
超大空间U型囊袋设计,留足空间,告别压迫更舒适。
自然挺拔的U凸设计,还能提升饱满的视觉效果。 穿着起来更加符合人体的生理结构。
臀部无缝设计,一体成型,告别尴尬~
传统裤腰每次脱下的时候,腰部像是背车轮碾过一样,火辣辣的疼。
此款采用宽腰带设计,舒适不紧绷。
无感烫印洗唛,没有磨人的标签水洗唛,舒适到忘记它的存在。
柔软亲肤、吸湿、透气、速干、抗菌、高弹性、耐穿少毛羽,一条内裤集齐了以上7个特点,真心可以召唤神龙了!还不赶紧来一条~
产品名:银离子防菌 U型囊防菌吸湿快干内裤
颜色:黑色+深蓝色 / 黑色+灰色
材质:43.5%兰精莫代尔+44.5%异形截面聚酯+11.5%莱卡+0.5%银离子
尺码:L / XL / XXL / XXXL
产地:中国
尺码参考
黑色+灰色(2条装)
黑色+深蓝色(2条装)